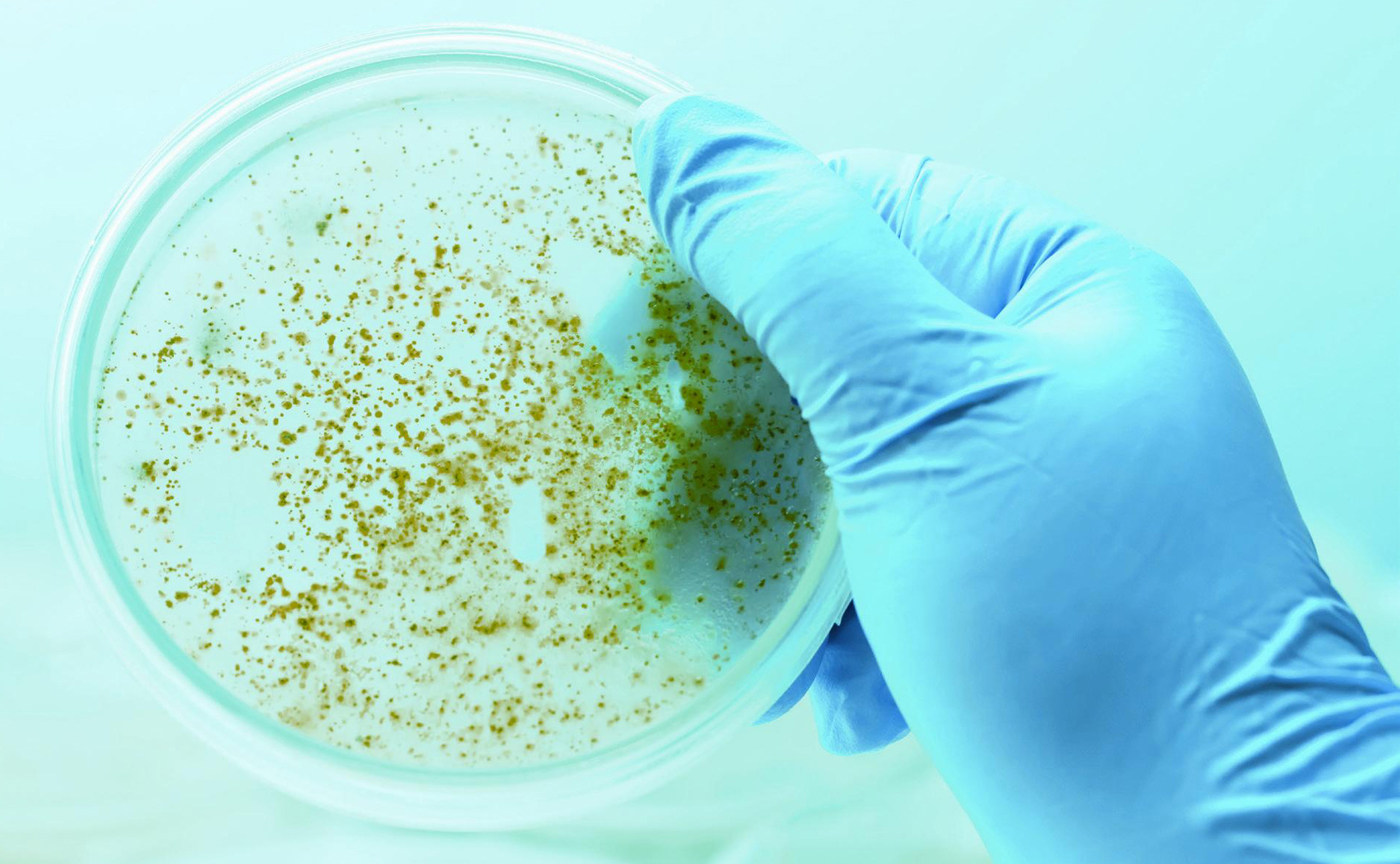

亿万年前的生命“氧”成记
今天,人们对氧气的存在已经习以为常。如果把时钟拨回到几十亿年前,回到生命刚刚在地球上立足的时代,我们会发现那时地球上根本没有氧气,地球大气的主要成分是甲烷、二氧化碳、水蒸气等。虽然地球上没有氧气,但宇宙中存在大量的氧元素。在衰老恒星的演化过程中,恒星核心通过核聚变合成了氧,所以宇宙中氧的含量还是比较丰富的,仅次于氢和氦。不过,因为氧特别容易和其他元素发生化学反应,所以绝大部分的氧是以某种化合物的形式存在。这类化合物被称为氧化物,其中最常见的就是水(H2O)。
据科学家推测,在地球诞生的早期,其表面有大量的水。也就是说,在几十亿年前的地球上,已经形成了浩瀚的海洋,但是没有氧气。地球上演化出的第一批生物从未见过氧气,它们通过无氧呼吸获取能量,同时利用化学能合成身体所需的有机物,其中一类化学能来自海底火山口。科学家通过研究海底火山口发现,其喷发的物质为周围的厌氧微生物提供了化学能。在这些微生物的基础上,一个生机勃勃的生态系统逐渐在海洋深处形成,虾、贝壳、管虫等多种生物生活于其中。因此,可以推测,在远古时代,一些海底火山口附近也同样存在由各种微生物组成的生态系统,它们可能是最早的地球居民。
蓝细菌开启“大氧化”时代
与仅存在于海底火山口的化学能相比,太阳能是地球上更为普遍的能源来源。现在,地球上的大部分生物依赖太阳能生存和繁衍。例如,植物可以利用太阳能将二氧化碳转变成有机物,这一过程就是光合作用。为了将二氧化碳转变为有机物就要设法还原二氧化碳,给二氧化碳提供电子。细胞中进行光合作用的叶绿体可被视作一个“泵站”,它利用太阳能提供的能量(类似于抽水泵利用电作为能量),从某个电子供体中抽取电子提供给二氧化碳。在距今约30亿年前,蓝细菌(也称蓝藻)“发明”了利用水作为电子供体支持光合作用的“技术”。也就是说,蓝细菌利用太阳能将水的氧原子的电子夺走,再传递给二氧化碳。这一过程必然伴随着水被不断地裂解并释放出氧气。所以,随着蓝细菌的繁殖,氧气就被源源不断地释放出来。一开始,氧气刚刚释放出来就会被消耗掉,这是因为氧气会与当时地球上还普遍存在的还原性物质(如氢气、铁等)进行反应,从而又回到了某种化合物的形态。当这些“缓冲物质”被耗尽后,氧气就逐渐在地球大气中积累。随着时间的推移,地球大气中终于出现了一定浓度的氧气。这段时期被称为“大氧化”时代,发生在距今约24亿—18亿年前。
“大氧化”对于绝大部分厌氧生物而言是灭顶之灾。这些生物从未见过氧气,当然也不会利用氧气。对它们而言,氧气是有毒的,氧气会与其细胞中的各种生物分子发生反应,破坏细胞的正常功能。所以,“大氧化”必然伴随着一波“大灭绝”。同时,氧气浓度的上升又给地球的生命体指出了一条新的演化道路—如果能利用氧气氧化有机物,那么这种生物便可以得到更多的能量。在这种情况下,能够利用氧气的生物会拥有更大的优势,它们的后代会逐渐在生物圈中占据统治地位并深刻地影响地球生物vK8335f54hd9d7s0Kw5GsczzrgRG3mztN0rky1IU3cI=的演化历程。
线粒体竟然来自远古的细菌
生物如何利用氧气获取能量呢?这还要从有氧呼吸谈起。
有氧呼吸是利用氧气氧化有机物获得能量的活动。在有氧呼吸的过程中,有机物通过化学反应“贡献”出它们的电子,细胞的“膜”上的一系列由蛋白质构成的分子机器则会将电子传递给氧气,使氧原子与氢原子结合形成水。这一电子传递过程与光合作用刚好相反,可以将其比作水电站发电,在“膜”上流动的电子是水流,“膜”上的分子机器则是水电站的水轮机。水轮机可以将水下落的势能转变成电能,而细胞里的水轮机输出的能量又以什么形式存在呢?科学家研究发现,在有氧呼吸的过程中,当电子在“膜”上向氧气流动时,细胞中的分子机器向“膜”的一侧泵出质子(也就是氢离子),从而在“膜”两侧建立质子浓度差,并利用浓度差驱动腺嘌呤核苷三磷酸(ATP)合成酶,从而进一步合成大量的ATP。细胞中的水轮机就这样将流动的电子产生的能量转换为以ATP形式存在的能量。利用ATP的水解,细胞可以完成各种耗能的化学反应。
对于细菌来说,上述过程发生在细菌的细胞膜上,前文所述的“膜”就是指细胞膜。复杂的、多细胞生物(如动物)的细胞结构和细菌有较大区别,它们的细胞在漫长的演化过程中“并购”了细菌,细菌的后代逐渐演化为细胞中的一个“部门”—线粒体,有氧呼吸就发生在线粒体的膜上。
线粒体是细菌的后代吗?如果人体细胞里有细菌的后代,那么病原体不是已经潜藏在人体中了吗?提起细菌,人们常常会认为它们都属于病原体。如果真的有某种致病细菌(如肺结核分枝杆菌)藏在人体细胞里,那么的确有可能引发疾病。然而,根据“细胞内共生”假说,在亿万年前,有一些细菌早已和我们远古时代的祖先达成了“协议”—细菌与生物细胞共同繁殖、演化,可谓“共命运,共荣辱”。这些远古的细菌实际上已经成为了“我们”的一部分。
通过研究现存生物的线粒体,科学家已经获得了大量证据,可以证明“细胞内共生”假说的合理性。与细胞内的其他结构(如细胞器)不同,线粒体有自己的DNA,其中包含了若干编码线粒体蛋白的基因,而且线粒体通过分裂增加自身数量。和细菌一样,线粒体需要先复制自己的DNA,然后分裂成两个新的线粒体。从基因序列上看,人体细胞的线粒体的基因更像细菌的基因,而不太像人类的基因。这些证据显示,线粒体很有可能是由远古的细菌演化而来的。
“有氧霸主”真核生物的优势
那么,这种“细胞内共生”关系又是如何形成的呢?让我们再回到“大氧化”时代一探究竟。
随着氧气浓度的上升,一个单细胞生物如果具有利用氧气氧化有机物从而获得能量的能力,它就会具有明显的竞争优势。所以,很多单细胞生物逐渐演化出了有氧呼吸的能力,但直到此时,地球上还没有出现真核生物。
什么是真核生物?真核生物是指那些人们通过显微镜可以看到其细胞核的生物,包括动物、植物、真菌、变形虫等。换句话说,几乎所有能形成复杂的多细胞个体的生物都是真核生物。在生命诞生的最初阶段,生物的细胞中没有具有核膜的细胞核,它们被称为原核生物。原核生物分为两类:一类是我们熟悉的细菌;另一类被称为古细菌。它们虽然都是单细胞生物,都没有具有核膜的细胞核,但是从DNA序列上看有很大的差异。从生物演化的角度看,细菌和古细菌属于两个不同的大家族。
今天,古细菌往往生活在极端环境中,比如,深海火山口或盐湖(如死海)。这类生物大多具有耐热、耐盐、耐碱、耐酸等特征。从外形上看,虽然古细菌与细菌比较相似,但是科学家通过仔细分析其基因发现,古细菌在很多方面更接近真核生物。
现在,有科学家提出了一种假说—真核生物是由古细菌演化而来的。在几十亿年前的某一个瞬间,一个古细菌吞噬了一个细菌,或者说一个古细菌和一个细菌“融合”为一个新型细胞,结果导致细菌变为细胞中的线粒体,专门为新型细胞的有氧呼吸提供“服务”。之后,这个新型细胞的后代又形成了具有核膜的细胞核(简称细胞核),并逐渐把大部分基因都转移到位于细胞核内的染色质上,从而完成了向真核生物的演化。储存在细胞核内的基因不仅包括古细菌的全部基因,还包括细菌的大部分基因(所以今天线粒体DNA中只携带了少数线粒体基因,大部分线粒体的基因还是在细胞核中)。细胞核为真核细胞带来了显而易见的优势,比如,与忙忙碌碌的细胞质分开,在细胞核中完成基因的复制和转录;因为DNA远离细胞质内的代谢活动(尤其是有氧呼吸),被破坏的可能性(如被氧自由基破坏)也随之降低。

与它的两个“祖先”相比,拥有线粒体和细胞核的真核细胞有很大的优势。线粒体为其提供充足的能量供应,细胞核则使其有足够的空间存放海量的遗传信息。如果将真核生物比喻为计算机,可以说,这台计算机拥有可以长时间续航的电池以及存储空间超大的硬盘。在这个基础上,细胞便可以演化出更加复杂的结构,执行更多的功能,同时运动能力也进一步增强。在此基础上,自然界演化出复杂的多细胞生物,如植物、动物,最后演化出能够思考、具有高级智慧的人类。
虽然已经打下了如此充分的基础,但生活于“大氧化”时代的生物还是长时间处于比较简单的状态。研究发现,从“大氧化”完成到距今约8亿年前,地球上并未出现复杂的多细胞生物。这段时间长达10亿年,科学家将之称为“无聊的10亿年”。是什么阻碍了多细胞生物的诞生呢?这个问题目前并无公认的答案,科学界也是众说纷纭。然而,有一个事实是无法忽略的,即在这10亿年中,虽然地球的大气中已经“有氧”了,但氧气水平仍然处于较低的水平,通常估计不超过今天的氧气水平的10%,甚至可能低至0.1%。
氧气水平较低导致细胞很难获得足够的能量,因此难以产生更积极的行为模式,也难以构建更复杂的组织结构。另外,也有学者认为,氧气水平较低可能有利于某些特定细菌的代谢活动,从而使海洋富含硫化氢。对于大部分生物而言,硫化氢具有毒性,因此也限制了生物的多样性发展。
不过,在“无聊的10亿年”的末期,这一切都随着地球氧气水平的上升而结束了。由于某种未知的原因,地球的氧气水平在距今约8亿年前开始上升,并且最终在“寒武纪大爆发”的前夕接近今天的水平。“寒武纪大爆发”是地球生命系统早期发生的一次爆发式增加事件。具体是指距今5.4亿—5亿年,地球海洋生命系统中“突然”出现了门类众多的后生动物(包括无脊椎动物和脊椎动物)。虽然出现“寒武纪大爆发”的原因目前科学界仍有争议,但是根据现有的科学证据可以推测,合适的氧气水平应该是其发生的一个必要条件。
在几十亿年前的地球上,氧气的故事起源于一个不起眼的蓝细菌细胞,随着蓝细菌种群的繁衍壮大,地球上的氧气水平一步一步提高。氧气浓度的增加带来了新的契机,原始的生命体开始向更复杂的方向演化,从单细胞到多细胞,从原核生物到真核生物,生物圈也日益丰富,直到距今约5.4亿年前的某一刻,地球上的生物跨过了“寒武纪大爆发”的门槛。在随后的几千万年里,地球上出现了迄今所知动物界中所有“门”一级成员的最初代表,而生命的演化也进入了一个繁盛的、全新的时代!
【责任编辑】张小萌